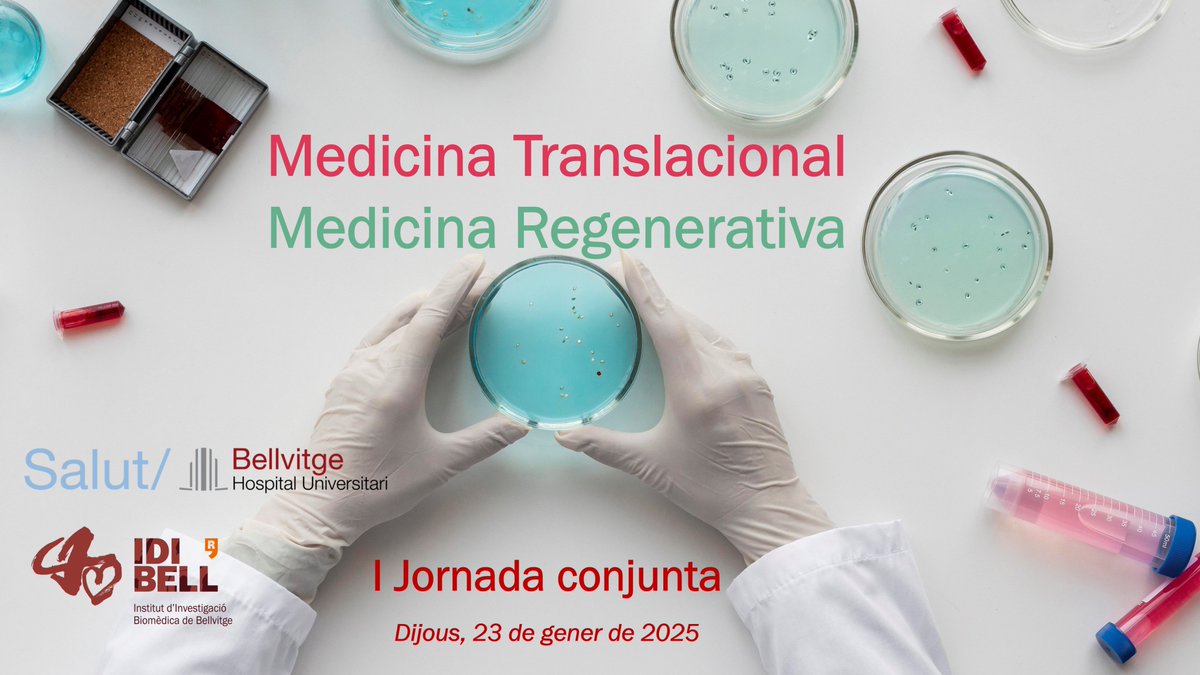

FlorianLab_StemCellAging
@florian_scaging
Understanding the biology of stem cell aging to improve the regenerative capacity of tissues and extend lifespan
ID: 1583423082643046401
https://p-cmrc.cat/research/florian-group/ 21-10-2022 11:42:05
179 Tweet
312 Followers
104 Following

📣 #ESHMICRO2025 CALL FOR ABSTRACTS ➡ bit.ly/3VcfYKN 5th Scientific Workshop Tumour Microenvironment & its Therapeutic Targeting 🗓️ Feb. 16-18, 2025 in London 🇬🇧 Chairs: D. Bonnet, Nitin Jain, Marina Konopleva, D. S. Krause, S. Mendez-Ferrer, K. Yong UCLH #ESHCONFERENCES


HAVE YOU CHECKED THE MAIN SCIENTIFIC TOPICS OF #ESHMICRO2025? ➡ bit.ly/3VcfYKN 5th Scientific Workshop Tumour Microenvironment & its Therapeutic Targeting Feb 16-18, 2025 Chairs: D. Bonnet Nitin Jain Marina Konopleva D. S. Krause, S. Mendez-Ferrer K. Yong #ESHCONFERENCES









Amazing presentation this morning by Esteban Hoijman 🔥🤯 2024 Regenbell Symposium day2 in beautiful Barcelona IDIBELL Session chaired by mireya plass (she/her)


🗓️ #ESHMICRO2025 STARTS ON FEBRUARY 16, 2025! Join us in London 🇬🇧 REGISTER NOW ➡ bit.ly/3VcfYKN 5th Scientific Workshop Tumour Microenvironment & its Therapeutic Targeting Chairs: D. Bonnet Nitin Jain Marina Konopleva D. S. Krause, S. Mendez-Ferrer K. Yong #ESHCONFERENCES


📣 MEET THE FACULTY OF #ESHMICRO2025 REGISTER NOW & join us in London on Feb. 16th➡ bit.ly/3VcfYKN 5th Scientific Workshop Tumour Microenvironment & its Therapeutic Targeting Chairs: D. Bonnet Nitin Jain Marina Konopleva D. S. Krause S. Mendez-Ferrer K. Yong #ESHCONFERENCES


Celebrem la I Jornada conjunta de Medicina Translacional i Medicina Regenerativa de l'#IDIBELL-Hospital Universitari Bellvitge | HUB. Una jornada adreçada a potenciar la interacció entre les dues àrees, augmentar el coneixement i generar o potenciar sinergies entre els investigadors del Campus Bellvitge.

Tres charlas del grupo FlorianLab_StemCellAging,que son master de secuenciar el ARN de células individuales, para instruirnos de células precursoras de células sanguíneas, de células de riñones trasplantados, y de mutaciones en leucemias.



Insightful talk on #ageing of the hematopoietic stem cells niche by Dr FlorianLab_StemCellAging at #ESHMICRO2025. See also doi.org/10.1002/1873-3… #aging #ESHCONFERENCES




Piero Carninci In Spain it works. Likely this is a first signal of distress about the funding cuts.

Abstract submission for the Molecular Hematopoiesis Workshop at European Hematology Association annual meeting in Milan is now open! Selected speakers get annual meeting registration; hotel accommodation; & travel reimbursement. More details and abstract submission here: ehaweb.org/congress/eha20…